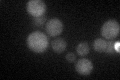
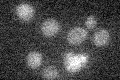

View description
Basic leucine zipper (bZIP) transcription factor (ATF/CREB1 homolog) that regulates the unfolded protein response, via UPRE binding, and membrane biogenesis; ER stress-induced splicing pathway facilitates efficient Hac1p synthesis
Localization:
Intensity:
Fold change:
Significance:
-
C’ GFP library in SD

below threshold16.43 -
N' NOP1pr-GFP in SD

N/A0 -
N' TEF2pr-mCherry in SD

N/A0 -
N' NATIVEpr-GFP in SD

N/A0 -
N' TEF2pr-VC and Cyto-VN in SD

N/A0 -
C’ GFP library in SD+DTT
cytosol14.030.85No -
C’ GFP library in SD+H2O2

cytosol15.410.93No -
C’ GFP library in Starvation Media
cytosol13.970.84No -
C’ GFP library on the background of Pup2-DaMP

below threshold -
C’ GFP library on the background of CCT mutant

below threshold16.59881.00971No
